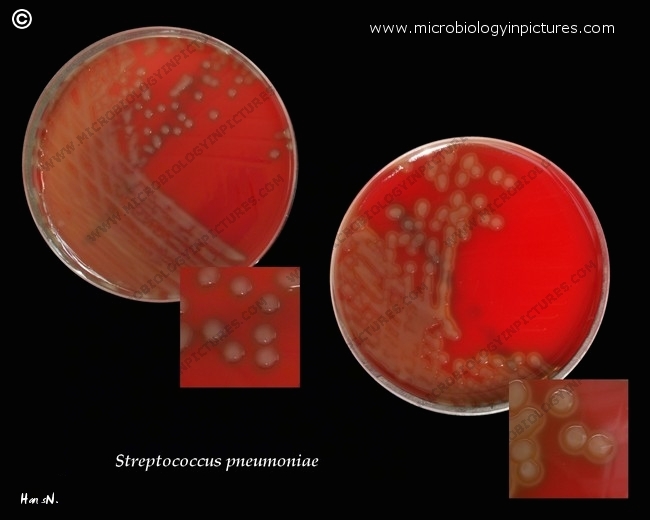

Two different virulent strains of Streptococcus pneumoniae. For virulent pneumococci production of capsules composed of complex polysaccharides is typical -see here. High production of these substances in some strains gives the colonies a typical glistening and mucoid appearance. Differences in the composition and, thus antigenic specifity of the capsule of different pneumococci have allowed the identification of more than 90 immunotypes. The physical nature of the polysaccharide capsule of the pneumococcus inhibits its engulfment by phagocytes and is therefore a major determinant of virulence.